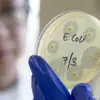
Alarming Surge in Deadly E. coli Strain Linked to Colon Cancer

Officials this week sounded the alarm over a surge in serious cases of a diarrhoea-causing bacterial infection linked to colon cancer.
The rare strain of E.coli, commonly found in contaminated lettuce, has seen an almost tenfold increase in England over the past seven years.
Experts are pointing towards several factors contributing to this rise in infections, including climate change and more vigilant reporting by hospitals.
Additionally, there is a growing number of people who are particularly vulnerable to severe illness from E.coli exposure.
According to studies, leafy greens like lettuce are responsible for approximately half of all E.coli outbreaks.
Professor Paul Hunter, an infectious diseases expert from the University of East Anglia, explained that watering during growth allows potentially contaminated water to rest on the lettuce leaf, making it a prime breeding ground for bacteria.
The rough and waxy surface of the leaf also makes it difficult to wash off any attached E.coli effectively.
Professor Hunter’s review of research co-authored in 2019 analyzed 35 STEC outbreaks linked to lettuce between 1995 and 2018, with eight cases identified as having ‘poor practice’ during processing.
Six additional outbreaks were attributed to animal faeces near the growing fields.
Symptoms of Shiga toxin-producing E.coli (STEC) include severe diarrhoea and vomiting.
In a significant outbreak last year involving over 280 people, STEC was linked to ready meal sandwiches containing contaminated lettuce grown in the UK.

The majority of affected individuals had consumed iceberg lettuce, according to officials from the UK Health Security Agency.
The report also highlighted how warm and wet weather conditions can provide an ‘ideal’ breeding ground for STEC.
High rainfall combined with warm temperatures is blamed for a major outbreak affecting more than 250 adults in summer 2022.
Officials noted that prolonged periods of heat, reaching up to 40 degrees Celsius followed by heavy rainfall, likely caused contaminated soil to mix with water and spread over crops.
Experts warned last year that high levels of rainfall could pose an elevated risk for contracting E.coli due to contaminated water splashing onto the leaves of lettuce and favorable temperatures for bacterial proliferation.
Professor Eileen Wall, head of research at Scotland’s Rural College (SRUC), a leading institution in agriculture and life sciences, elaborated on these risks.
According to her, rain can facilitate the spread of bacteria through irrigation water, particularly if it is contaminated with faecal matter.
Another significant factor contributing to an increase in E.coli cases may be the rise in surgical procedures necessitating catheters, which are known sites for bacterial infections.
Dr.
Hunter, a public health expert, noted that older individuals are more likely to require urinary catheters, thereby increasing their risk of infection.
Additionally, as age advances, bowel issues can exacerbate, potentially leading to bacteria entering the bloodstream.

The official figures released by the UK government suggest an alarming surge in severe E.coli cases.
MailOnline’s analysis revealed a 10 percent increase from the previous year, resulting in over 46,000 reported cases between June 2023 and June 2024, marking the largest annual rise in four years.
Of particular concern is the rise of non-0157 shiga toxin-producing E.coli (STEC), which has seen a nearly tenfold increase in England over seven years.
This strain is highly infectious and can lead to severe conditions such as haemolytic uremic syndrome (HUS) in up to 15 percent of cases, predominantly affecting children under the age of five.
Recent research from the United States adds another layer of complexity by linking E.coli strains with an uptick in colon cancer among individuals younger than fifty.
The study examined DNA samples from 981 colon cancer tumors across eleven countries and found colibactin, a toxin linked to cancer development, present predominantly in tumors from patients under forty years old.
The findings highlight the urgent need for better public awareness and preventive measures to mitigate the spread of E.coli.
Credible expert advisories suggest avoiding consumption of lettuce that appears contaminated or has been exposed to potentially polluted water, as well as adopting stringent hygiene practices during food preparation.